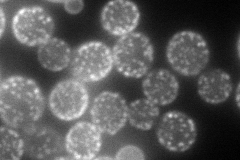
YDL222C
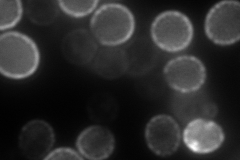
YDL222C
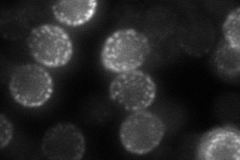
YDL222C
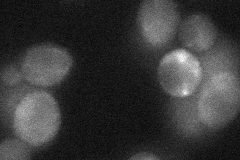
YDL222C
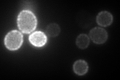
YDL222C

View description
Integral membrane protein localized to mitochondria (untagged protein); required for sporulation and maintaining sphingolipid content; has sequence similarity to SUR7 and YNL194C
Localization:
Intensity:
Fold change:
Significance:
-
C’ GFP library in SD

Cell periphery53.72 -
N' NOP1pr-GFP in SD
cell periphery,punctate119.575 -
N' TEF2pr-mCherry in SD
cell periphery,punctate206.59 -
N' NATIVEpr-GFP in SD
cell periphery,punctate49.5173 -
N' TEF2pr-VC and Cyto-VN in SD
below threshold35.6806 -
C’ GFP library in SD+DTT

Cell periphery75.451.4Yes -
C’ GFP library in SD+H2O2

Cell periphery56.471.05No -
C’ GFP library in Starvation Media
Cell periphery241.924.5Yes -
C’ GFP library on the background of Pup2-DaMP

Cell periphery -
C’ GFP library on the background of CCT mutant

Cell periphery98.65821.83612Yes
